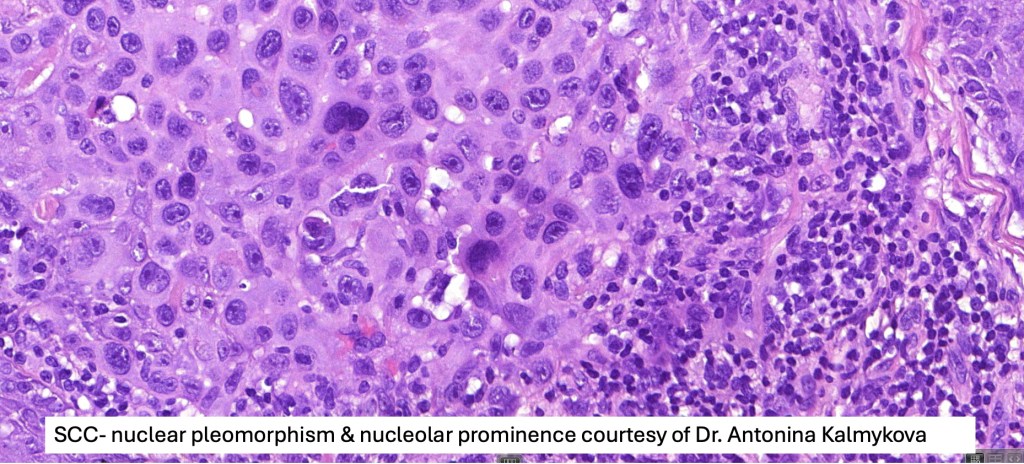
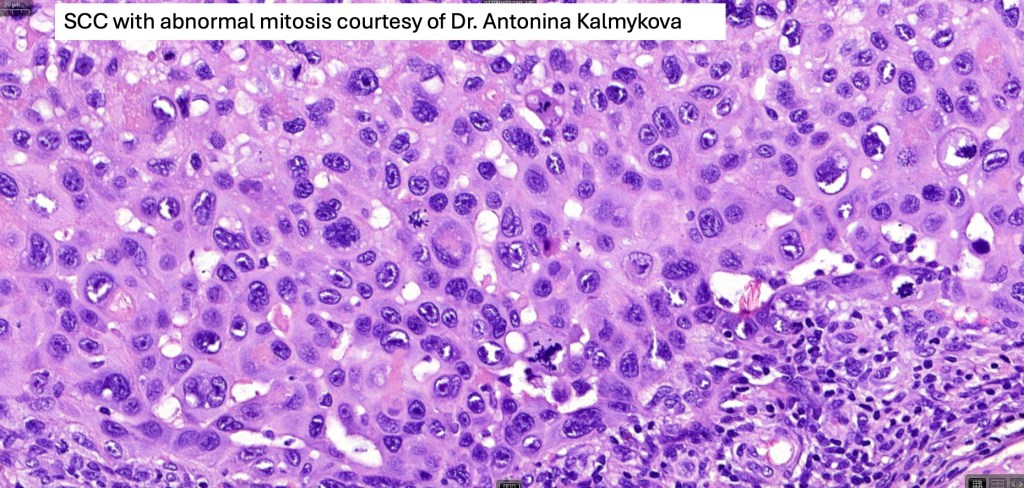
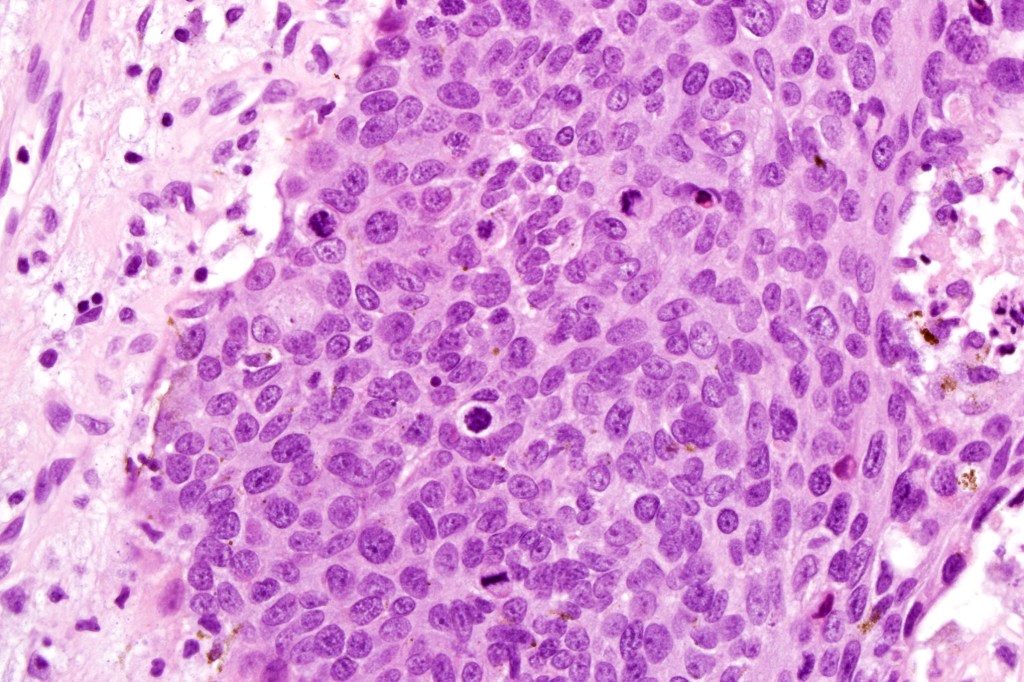

Clinical features
•2nd commonest malignant skin tumor after BCC (1:4)
•Etiology includes UVB, HPV, ionizing radiation, scarring e.g., burns, syndromic e.g., xeroderma pigmentosum, albinism, Rothmund-Thompson syndrome & epidermolysis bullosa, immunosuppression, PUVA, chronic infections e.g., tuberculosis, arsenic & coal tar derivatives
•Type I and II skin
•M=F
•Generally middle aged or elderly but may arise in at risk children
•Sun-exposed skin most often affected- face, neck, arms & hands & the scalp in bald patients
•Lesions on the lips & ears are particularly aggressive (metastasis rates 11 & 13 respectively)
•Overall metastasis rate- 5%
•Variably ulcerated, scaly macule, nodule or plaque
•Pigmented variant
•Genital and subungual SCC are discussed in separate blogs













Histological features
•Varying degrees of squamous differentiation- well, moderate, poorly, undifferentiated & anaplastic
•Precursor lesion –actinic keratosis, PUVA keratosis & Bowen disease
•Generally, an infiltrative lower border but exceptionally, may be pushing
. Presence of desmosomes, individual cell keratinization, keratin pearls, keratocysts
•Variable pleomorphism
•Nucleolar prominence
•Mitoses typically numerous & may be atypical
•Variable perineural infiltration & lymphovascular invasion
•Variants include verrucous, acantholytic, follicular, clear cell, spindle cell, metaplastic (squamous carcinosarcoma, desmoplastic, pseudovascular & keratoacanthoma (see separate bogs)
•AE1/AE3, p63, p40, EMA, CK5/6 +ve
•CAM5.2, CK7, CK20, BerEP4 -ve

Grading SCC
This has some limitations as for example squamous carcinoma in patients with dystrophic epidermolysis bullosa is typically well differentiated and yet it is associated with very high mortality. Perhaps of greater importance is the site of the tumor. Those on the lip, ear, scalp & nose are associated with a much poorer prognosis than elsewhere.

Leave a comment